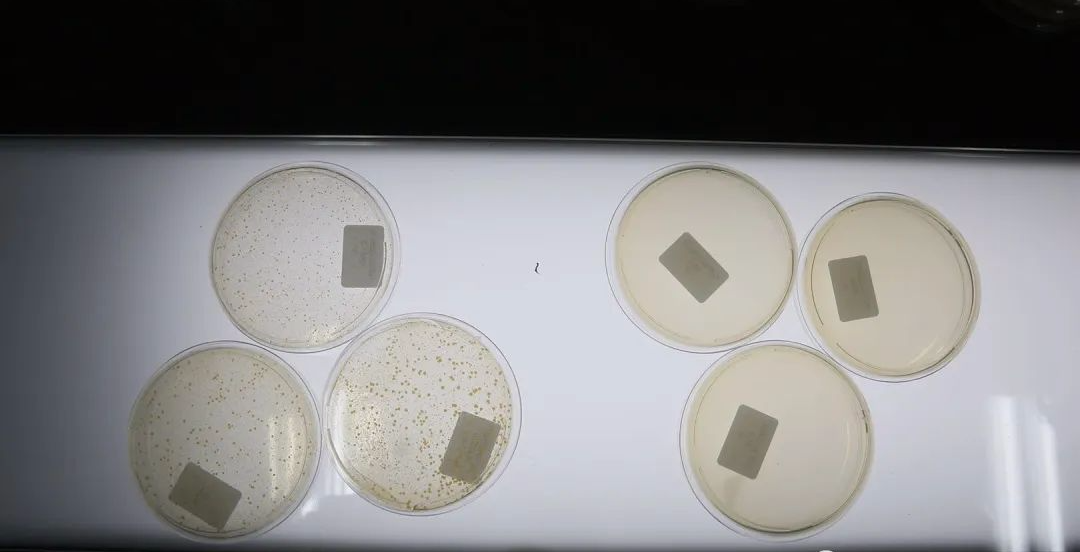

非常时期,日常的杀菌消毒不能含糊,尤其快过年啦,更要格外小心喽
病菌通常附着在我们日常接触到的东西上
手接触到口鼻
进而导致感染!

日常保护措施也要齐全
千万不要因为一时疏忽大意
造成大祸

酒精适用于手机、遥控器、电脑键盘
桌椅等物体表面消毒
不宜往空气中喷洒
遇明火或静电
可能会燃烧
84消毒液杀菌灭病毒能力强
但刺激性和腐蚀性也强
使用前需提前勾兑
喷洒后很难避免儿童宠物舔舐

又好又有效的消毒方法莫过于紫外线了
紫外线消毒灯,随开随用
对空气和物体表面等均可消毒
使用期间避免照射到人体和动植物即可

那小伙伴可能就说了
总不能回趟家一直扛着个灯吧
这不就有一款
方便携带还能当收纳包的
多功能消毒包
可以用它给
口罩、围巾、护目镜(要注意其材质是否耐高温)消毒

放不下的物品还可以拆下消毒棒
直接扫一扫消毒
出差时浴室里潮湿的浴缸、马桶
都是病菌的集中营
一定要重点照顾下
更加放心好入睡

冰箱里食物混杂的异味
用这个杀菌棒来回多扫几次杀菌后
异味竟然也会消失

最重要的是还可以给个人贴身衣物消毒!

内衣裤是女人重要部位的“保护伞”
我们每天穿着十几二十小时
很容易衍生各种分泌物和细菌
如果不注意它的清洁和除菌
很容易就患上不明不白的“妇科病”
特别很多人为了图方便
“一锅乱炖”的方式洗衣服
经常直接把内衣裤跟衣服
一起丢进洗衣机里滚滚就完事了
最多就是加个内衣专洗袋
千万不要这样做啊!
洗衣机本身就是个
“大型的细菌滋生温床”

普通的肥皂,清洗剂
根本就洗不干净
而且太多化学物质会
刺激私处,有残留
十有八九引起健康问题

而且洗好一般要在阳光下暴晒6个小时
但是如果达不到日晒时间
最好在清洗时就采取消毒手段
这也太麻烦了吧!
没关系
我们有同时照顾到
健康和麻烦
两个问题的贴身衣服消毒神器
多功能便携式内衣消毒包

有了这个消毒袋
只需要三步
打开拉链放进去
拉上拉链按下钮等待3分钟
拿出来就好了

它适合:所有女性。尤其适合工作繁忙的女性、有妇科困扰的女性、孕妇,以及生娃后的老母亲,并且适用所有织物产品。

不管是夏天还是春秋冬季
日晒6小时都不太好实现

用小矿鼠消毒包
放进去,按下开关
只需要3分钟就完成了整个消毒过程
臭氧+UV紫外线杀菌
可快速穿透病菌细胞膜
从而有效去除衣物上的病菌
安全放心

一个跟化妆包大小的消毒包
只需3分钟
就能把孩子用的奶瓶、衣物、玩具
甚至口罩和贴身衣物进行消毒
还能延长口罩使用时间
并且宣称细菌杀灭率高达99.9%
这是真的吗?

最新一期质量公开课
鉴定评测实验室“质量公开课”
同SGS专家一起测试了这款“灭菌神器”

SGS电子技术经理叶汉翔介绍
这类产品在早几年就已兴起
当时主要用于奶瓶等产品消毒
疫情后
这类消毒产品需求增大
同时其具有消毒时间短、操作便携等优点,适合现代快节奏的生活。

工程师对消毒包进行杀菌有效性测试

左:未消毒的参照组 右:经过消毒包消毒的实验组
实验结果表明,该款紫外线消毒包对这两种细菌的杀灭对数值均大于3.00(杀灭率大于99.99%),说明是能达到一定的杀菌效果的。

ps:在使用紫外线杀菌灯时要注意不要直接照射到人体皮肤,更不能直接用眼睛去直视灯管。

这款消毒包一键操作用法简单
特别适合忙碌的现代女性、孕妇
还有恨不得有三头六臂的老母亲
而且它还能包容你娇嫩的真丝内衣
防病毒口罩,以及小朋友的玩具
使用方法的视频👇:
紫外线LED,杀菌99.9%
确保360度无死角

选用医用紫外线灯
对日常所见的大部分病菌
病原体都有显著效果
里面的LED灯珠发射的紫外线
可以破坏细菌、病毒的DNA或RNA
达到99.9%的消毒效果

私处常见各种病菌
霉菌、滴虫菌、大肠杆菌、葡萄球菌
沙门氏菌“白色念珠菌
用了它统统拜拜!

官方出具的国家检测证明:


它具备汞灯的医用级别消毒水平
却比汞灯更安全,操作更简单
和其他传统消毒方式相比
它是最具优势的

照射3分钟还能去除衣物上的霉味
从内衣消毒包里面拿出来的衣物
和在太阳下曝晒后的被子
是一样干净清新的味道

对于宝妈而言
它还可以用来消毒宝宝的衣物,奶瓶
或者自己的牙刷,化妆工具
一袋多用,性价比非常之高

孕期、哺乳期的妈妈分泌物增多
更需要保持内裤、内衣的卫生
用一个小盒子就能解决消毒的所有问题
简直太贴心了

对于妈妈来说最操心就是宝宝的安全了
新生宝宝基本上就是靠嘴巴感受世界
尤其是六个月后活动能力强的宝宝
抓到什么吃什么

要是有了这个消毒包
妈妈们就可以轻松很多啦!
不仅是宝宝的一些餐饮用具
吸奶器、牙刷、围兜、牙胶也都用它来消毒
定期给贴身衣服、t恤
口水巾等小件衣物消毒
可以减少宝宝过敏现象

还有独家的外观专利
有效防止假冒伪劣
能当做收纳包装进行李箱
还可以带上飞机
做工上也不输大牌
带出去就像是一个大牌化妆包一样

粉粉的外表
带出去出差旅行也不会尴尬
轻便好携带
就像一个化妆包

除了消毒内衣
毛巾口水巾、化妆刷、彩妆蛋、宝宝衣物
尿不湿、玩具玩偶
统统都能消毒
一盒多用

本品专门设置儿童锁保护
防止宝宝误触开启

这款99.99%消除细菌、病毒的消毒黑科技,真可谓是“行走的消毒柜”啊!
解决了居家出行的消毒需求,可以让我们每时每刻都享受有阳光般的感觉,给宝宝和自己一个安全的屏障,防止细菌交叉感染。
